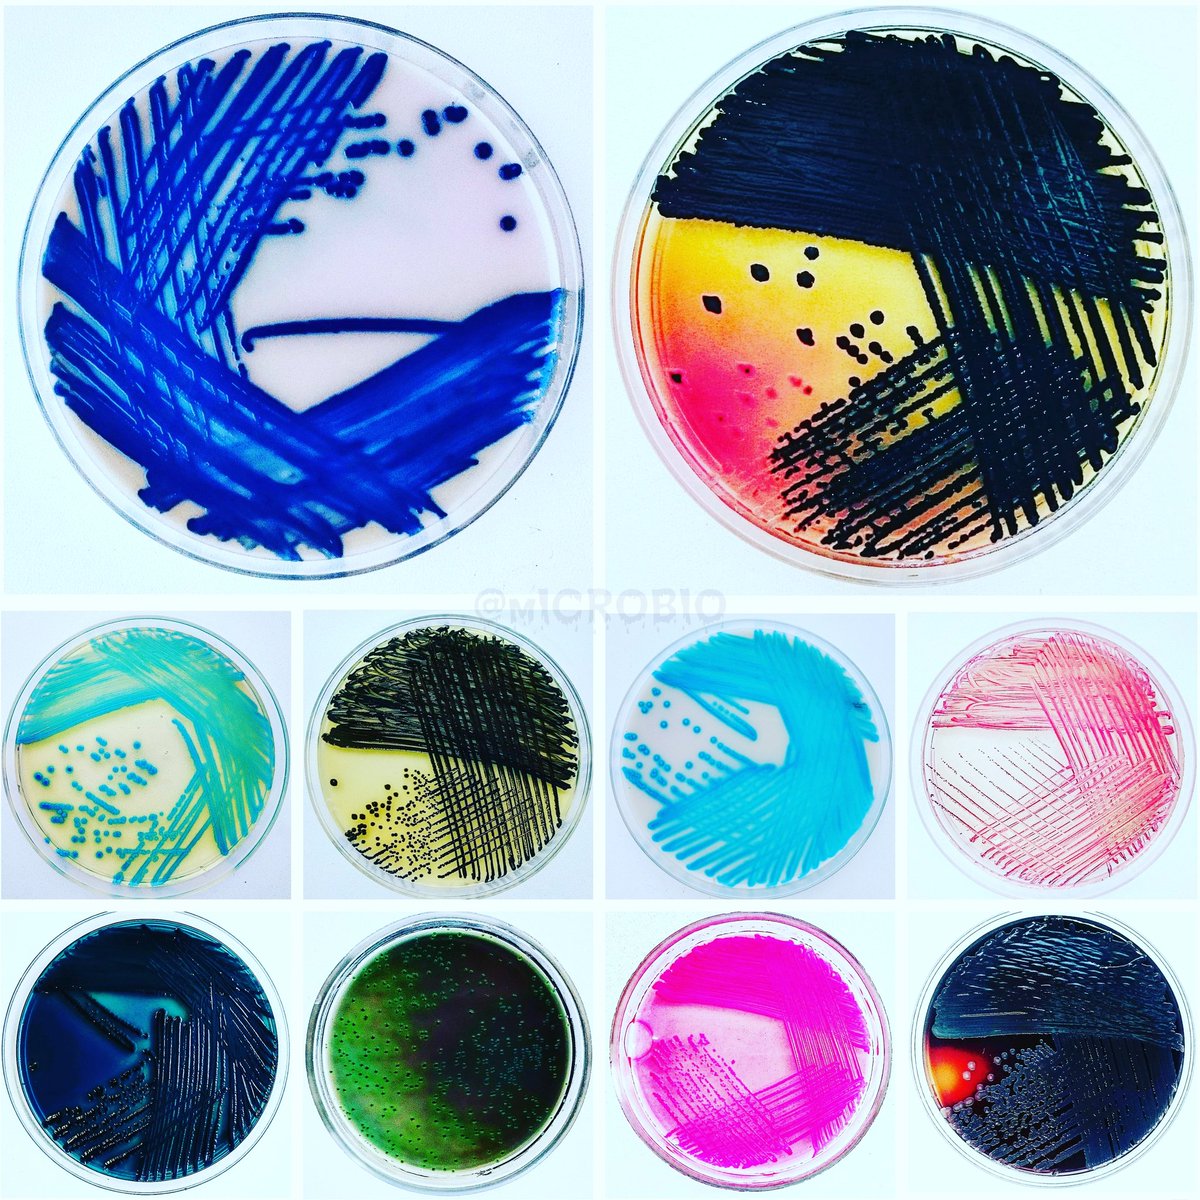
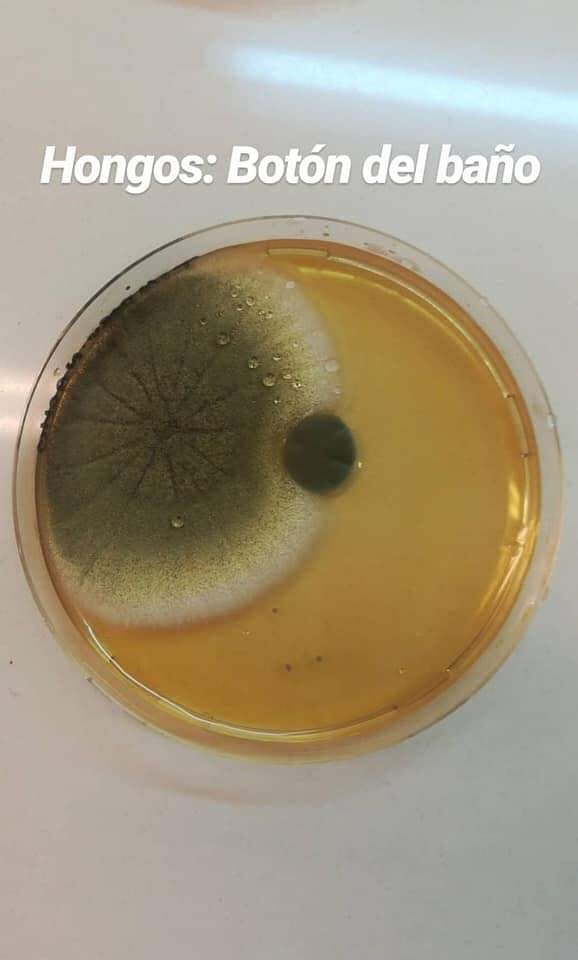
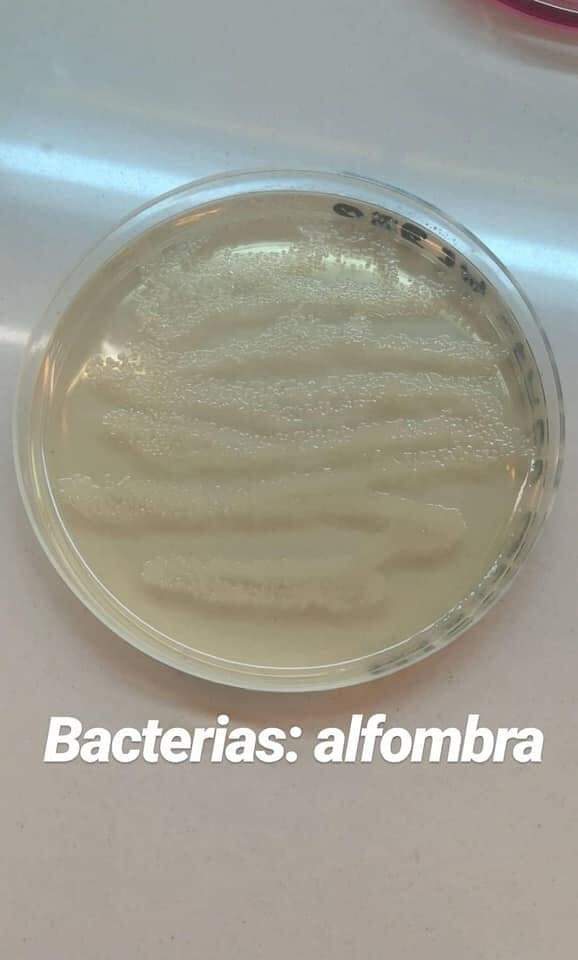

#microbes نتائج البحث
Review by Brito-Lopez et al. @WageningenUR @WURenvironment @royalsociety Plant growth–promoting #microbes & #microalgae-based #biostimulants: #sustainable strategy for #agriculture & #abiotic stress resilience royalsocietypublishing.org/doi/10.1098/rs… @sci_plant @Biostimulants @BiostimulantAg


♦#Pasteurdon2025 #épidémies #microbes résistants… La recherche a besoin de nous ! Pour faire un don ⤵ ☎️3620 📲 Par SMS en envoyant "DON" au 92112 💻pasteurdon.fr 𝗣𝗼𝘂𝗿 𝗰𝗵𝗮𝗾𝘂𝗲 𝘃𝗶𝗲, 𝗹𝗮 𝘀𝗰𝗶𝗲𝗻𝗰𝗲 𝗮𝗴𝗶𝘁 @institutpasteur #Pasteurdon…

ISME Communications is expanding its scope to include Taxonomy and Nomenclature, recognizing their essential role in microbial ecology. Read more: isme-microbes.org/taxonomy-and-n… #microbes #taxonomy

Two weeks left for students and postdocs to apply to receive support for international research, training, or lab visits. Submit your application by 1 October 2025! Learn more and apply: 🔗isme-microbes.org/isme-scholar-m… #MicrobialEcology #microbes

♦#Pasteurdon2025 #épidémies #microbes résistants… La recherche a besoin de nous ! Pour faire un don ⤵ ☎️3620 📲 Par SMS en envoyant "DON" au 92112 💻pasteurdon.fr 𝗣𝗼𝘂𝗿 𝗰𝗵𝗮𝗾𝘂𝗲 𝘃𝗶𝗲, 𝗹𝗮 𝘀𝗰𝗶𝗲𝗻𝗰𝗲 𝗮𝗴𝗶𝘁 @institutpasteur #Pasteurdon…

We are looking for photos or videos of microscopy images and microbial ecologists at work! The winning photos and videos will be used to promote the ISME Society and of our publications. Submit your entry by 11 November! 🔗isme-microbes.org/call-for-micro… #MicrobialEcology #microbes

In #Microbiome 🚨Assessing the potential of #seawater #microbes to be used as indicators of #reef health🦠🪸 📢Functional info in reef-associated seawater microbes more robustly associates with physico-chemical variables than #taxonomic data🌊🪸 👉doi.org/n3cm

Last chance to send in your application to the ISME Scholar Mobility Fund to visit a host institution outside of your country of study. The deadline is tomorrow! Learn more and apply: 🔗isme-microbes.org/isme-scholar-m… #MicrobialEcology #microbes

The ISME Early Career Scientist Committee and ISME Publications welcomed 102 early career scientists to the inaugural ISME Early Career Scientist Reviewer Pool. Read more on isme-microbes.org/isme-launches-… #MicrobialEcology #microbes

#cancers #épidémies #microbes résistants… la recherche a besoin de nous ! Chaque voix compte, chaque don compte lui aussi Vos dons sur pasteurdon.fr #Pasteurdon @institutpasteur @Val_Brochard

Deep-sea #microbes & #antibiotic resistance! @CSIRCSMCRI1 profiled #bacteria from the #ArabianSea (5–3000m) & uncovered hidden reservoirs of antibiotic resistance — vital for #marine #health & global surveillance. Read the study: doi.org/10.1016/j.marp… @DrJitendraSingh…

Congratulations to the next round of IMD event organisers, selected from Brazil, China, Latvia, and Belgium. Thank you for joining forces with #InternationalMicroorganismDay to help educate the local community about the importance of #microbes and their diverse applications.




YES!!Excellent initiative #Microbes-for-Climate #M4C🦠FUNDED💲💰☺️🤩 The best?🤔The people❤️ Endless gratitude to Tobi&Anke- amazing role models❤️ Love the "thanks BBQ no matter what" spirit from the "Präsidium"! Sure it tasted better as we got it😉😂 #ProfLife #LovelyMarburg🏰❤️

Welcome Streptomyces dubilierae! 😀 Our director @NicoleDubilier is having a strain named after her, honouring her contributions to the study of #symbioses of #microbes. Congratulations, and many thanks to the appreciating researchers @Leibniz_DSMZ_en!👏🎉🦠🎊 @maxplanckpress

Terreplenish® microbes clean ponds naturally—breaking down excess nutrients, reducing algae, and restoring water clarity without chemicals. #microbes #cleanwater #SustainableFarming youtu.be/LZro8JEMqXw
Plant Roots Farm & FEED On #Microbes!! Learn about #Rhizophagy with #RegenerativeSoil: thepermaculturestudent.com/shop/regenerat…

#cancers #épidémies #microbes résistants… la recherche a besoin de nous ! Chaque voix compte, chaque don compte lui aussi Vos dons sur pasteurdon.fr #Pasteurdon @institutpasteur @Val_Brochard

♦#Pasteurdon2025 #épidémies #microbes résistants… La recherche a besoin de nous ! Pour faire un don ⤵ ☎️3620 📲 Par SMS en envoyant "DON" au 92112 💻pasteurdon.fr 𝗣𝗼𝘂𝗿 𝗰𝗵𝗮𝗾𝘂𝗲 𝘃𝗶𝗲, 𝗹𝗮 𝘀𝗰𝗶𝗲𝗻𝗰𝗲 𝗮𝗴𝗶𝘁 @institutpasteur #Pasteurdon…

♦#Pasteurdon2025 #épidémies #microbes résistants… La recherche a besoin de nous ! Pour faire un don ⤵ ☎️3620 📲 Par SMS en envoyant "DON" au 92112 💻pasteurdon.fr 𝗣𝗼𝘂𝗿 𝗰𝗵𝗮𝗾𝘂𝗲 𝘃𝗶𝗲, 𝗹𝗮 𝘀𝗰𝗶𝗲𝗻𝗰𝗲 𝗮𝗴𝗶𝘁 @institutpasteur #Pasteurdon…

🤝MedChemExpress on the Move in France | #Microbes 2025 Thank you to everyone who met and exchanged with us during this inspiring event! We were thrilled to share our microbiology research solutions and unveil our limited “#Pink #October” goodies 💗 supporting breast cancer…



The secret to fine #chocolate isn’t just in the beans—it’s in the #microbes that ferment them. University of Nottingham research shows yeast & bacteria #ferment cocoa into rich, fruity, and floral flavors. sciencenews.org/article/chocol…

Some products of fiber digestion by #gutmicrobes, such as butyrate and propionate, can alter gene expression and exert anti-tumor effects You are what your #microbes do with what you eat: gutmicrobiotaforhealth.com/fiber-and-canc…
Something that gets our brain's going a little 🤯... Microbes helped shape Earth’s atmosphere billions of years ago — and they’re still shaping our world today. 🌍✨ #FunFact #Microbes #Facts #BeneficialMicrobes #MicrobesMatter #Earth
Dans la salle de bain, mieux vaut appliquer le chacun pour soi. #salledebain #microbes #virus pourquoidocteur.fr/index.php?op=A…
Opinion piece: To effectively conserve #ecosystems, you must also conserve #microbes. Here’s a plan that supports both traditional #conservation goals while offering adaptations to conserve #microorganisms themselves. ow.ly/NEHu50X7Pu6 #biodiversity

ISME Communications is expanding its scope to include Taxonomy and Nomenclature, recognizing their essential role in microbial ecology. Read more: isme-microbes.org/taxonomy-and-n… #microbes #taxonomy

MICROBIOLOGY STUDENTS, THIS IS A MUST HAVE! 👀 A flowchart in identifying the Clinically Significant Gram Positive Cocci with some side notes 🧫 Here's the google link for the jpg file! Share this to your friends 🤓🦠 drive.google.com/file/d/1YPP1SM… #Microbiology #Bacteriology 🤓🧫

The Many Shapes of Bacteria #bacteria #infographic #microbes #microbiology #science #bacteriology #biology #morphology #scientificart

How humans and animals are silently fueling Antimicrobial Resistance (AMR) Antimicrobial resistance didn’t appear overnight. We helped it grow — in our homes, farms, and even hospitals. Here’s how 👇🏽

NEW PIECE: The Many Shapes of Bacteria ⚪️🧫⚪️ #bacteria #microbes #infographic #art #sciart #scientificart #colony #microbiology #microorganisms #biology #microscopy #germs #science #illustration #petri #infographics

Y por si alguno quiere tener esto en imagen os dejo un mindmap de bacterias que llevo arrastrando desde 3 de carrera y me ha venido muy bien para consultar de vez en cuando

Esta imagen de microscopía nos muestra glóbulos multicolores, marcados genéticamente con proteínas fluorescentes, que pueden rastrear el linaje celular clonal. 🌈🎨 DOI: 10.1126/science.acx9495

penicillin fungus under the electron microscope

amoeba (unicellular organism) under the electron microscope

1) Escherichia coli. 🦠 2) Staphylococcus spp. 🦠 3) Klebsiella pneumoniae. 🦠 4) Staphylococcus aureus. 🦠 5) Pseudomonas aeruginosa. 🦠 6) Micrococcus spp. 🦠

I am so happy to share my entry for #MicrobeArt2020 @FEMSmicro Agar is just another fun media you need to use when you are a sciartist 😉 We all harbor a gigantic treasure: our microbiome! The bacteria used were isolated from human mouth/skin. #InternationalMicroorganismDay


💚💛🧡❤🖤 1) Klebsiella pneumonia, Hicrome agar. 2) Citrobacter freundii, Ploskirev bactoagar. 3) Listeria innocua, ALOA agar. 4) Staphylococcus spp, Baird-Parker agar. 5) Enterococcus faecalis, Hicrome agar. 6) Enterococcus faecalis, Enterococcus agar. #microbiology
Root barriers and metabolite leakage shape microbial colonization of plants. Learn more in a new #SciencePerspective: scim.ag/4q09DyK

Imágenes de un general de heces 💩 de un paciente con diferentes tipos de parásitos; échale un vistazo a este hermoso zoológico donde verás, Quistes de Entamoeba coli, Entamoeba histolytica, Giardia lamblia, Iodamoeba butschlii, huevecillos de Hymenolepis nana




🧫Mira los microorganismos con las que a diario convivimos y a simple vista no las vemos, pero siempre están ahí.

Hoy es el #InternationalMicroorganismDay así que aprovecho para recordar que la mayoría de los microorganismos son nuestros "amigos" ¡desterremos su mala fama! 🦠🧫🔬 Virus, bacterias, hongos filamentosos, levaduras y protistas que nunca dejan de sorprendernos 😊




Molecular mechanisms of host-microbiome interactions: We teamed up w/@CellChemBiol for a Collection of articles uncovering mechanisms by which microbes communicate with their hosts, shedding light on various conditions & offering therapeutic avenues.Enjoy! cell.com/cp/collections…

Something went wrong.
Something went wrong.
United States Trends
- 1. Good Sunday 43.9K posts
- 2. Discussing Web3 N/A
- 3. Auburn 46.8K posts
- 4. MACROHARD 7,522 posts
- 5. Brewers 66.6K posts
- 6. Gilligan's Island 5,087 posts
- 7. Wordle 1,576 X N/A
- 8. #SEVENTEEN_NEW_IN_TACOMA 38K posts
- 9. #MakeOffer 20K posts
- 10. Kirby 24.7K posts
- 11. #SVT_TOUR_NEW_ 30.2K posts
- 12. Boots 51.6K posts
- 13. QUICK TRADE 2,384 posts
- 14. #HawaiiFB N/A
- 15. #BYUFOOTBALL 1,029 posts
- 16. FDV 5min 2,294 posts
- 17. Utah 25.6K posts
- 18. Holy War 2,102 posts
- 19. Dissidia 7,092 posts
- 20. mingyu 107K posts